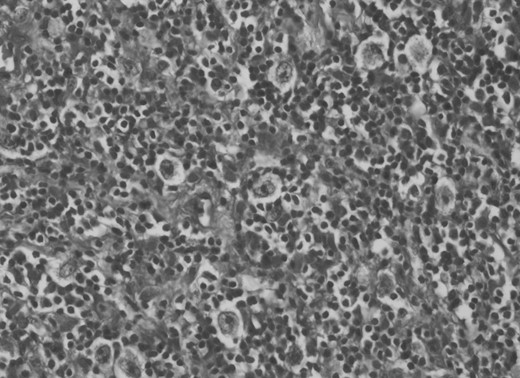
Histological examination revealed mixed cellularity type of Hodgkin's lymphoma.

-
PDF
- Split View
-
Views
-
Cite
Cite
Onur Yaman, Nail Özdemir, İsmail Ertan Sevin, Füsun Demirçivi Özer, Saime Ünlüoğlu, Primary spinal epidural Hodgkin's lymphoma, Journal of Surgical Case Reports, Volume 2013, Issue 10, October 2013, rjt090, https://doi.org/10.1093/jscr/rjt090
Close - Share Icon Share
Abstract
Primary spinal epidural Hodgkin's lymphoma is very rare. We will discuss the clinical features and treatment of primary spinal epidural Hodgkin's lymphoma. In this paper, a 30-year-old male patient who presented with spinal epidural tumor at the T9–11 level is reported. Subtotal resection of the tumor was performed and the histological examination of the tumor specimen revealed Hodgkin's lymphoma. All other examinations were negative for an occult disease. Six courses of chemotheraphy containing adriamycin, bleomycin, vinblastine and dacarbazine were given to the patient. Surgery is the first therapeutic approach in malignancies compressing the spinal cord. Hodgkin's lymphoma is a very chemo- and radio-sensitive tumor. The indications for surgery were reduced and limited to laminectomy or even biopsy only, leaving the major role to chemo- and radiotheraphy.
INTRODUCTION
Most patients with Hodgkin's disease and spinal epidural involvement either present with concurrent neurological and nodal disease or develop neurological disease after being diagnosed with Hodgkin's disease [1]. Primary Hodgkin's lymphoma of the spinal epidural region is extremely rare. A case of a 30-year-old male patient with primary thoracic epidural lymphoma who presented with back pain is presented in this paper.
CASE REPORT
A 30-year-old male patient was admitted to our clinic with back pain. Pain was provoked by movements. The severity of pain was associated with the inability to perform the activities of daily living. The patient did not have any lymphoma-related B-type symptoms, including body weight loss, fever and sweat at night. He did not have a past and family history. There was no neurological deficit. Routine laboratory test results were normal. A magnetic resonance imaging (MRI) scan of the thoracic spine demonstrated an epidural tumor at the T9–11 level (Figs 1–3). The patient underwent spinal cord decompression via total laminectomy of T9–11 levels. Subtotal resection of the tumor was performed. Histological examination revealed the polymorphous cellular infiltration by histiocytes, large mononuclear cells and lacunar Reed–Sternberg cells with folded multi-lobed nuclei and small nucleoli (Fig. 4). Immunohistochemical staining was positive for CD15 and CD30 and negative for CD3, CD20, CD79a or CD45Ro. These features were most frequently observed in the mixed cellularity type of Hodgkin's lymphoma. Histological examination of the vertrebral body revealed no abnormality. The results of all other examinations (F-18 fluorodeoxyglucose positron emission tomography (F-18 FDG PET/CT), bone marrow biopsy and computed tomography (CT) of the chest, abdomen and pelvis) were negative for an occult disease. The patient was referred to the hematology department to undergo staged treatment. Six courses of chemotheraphy containing ABVD regimen (adriamycin, bleomycin, vinblastine and dacarbazine) were given to the patient. Postoperative MRI scan did not reveal any evidence of Hodgkin's disease (Fig. 5), F-18 FDG PET/CT, CT of the chest, abdomen and pelvis were obtained in 24 months and did not reveal any evidence of Hodgkin's disease.

Histological examination revealed mixed cellularity type of Hodgkin's lymphoma.

Postoperative MRI scan did not reveal any evidence of Hodgkin's disease.
DISCUSSION
The incidence of spinal epidural Hodgkin's lymphoma is <5%. Patients with Hodgkin's disease develop spinal cord compression caused by epidural Hodgkin's lymphoma and usually observed in the presence of an advanced disease [1, 2]. Primary spinal epidural localization is very rare in Hodgkin's lymphomas.
There are six case reports in the literature that describe patients with primary spinal epidural Hodgkin's lymphoma [1–6] (Table 1). Samadian et al. [2] reported a case of primary and isolated spinal epidural Hodgkin's lymphoma at L1–L3 level. After surgery, the patient received a combination of chemotheraphy and radiotheraphy. Al-Khayat et al. [1] reported a Hodgkin's lymphoma case with epidural involvement at C7–T1 level. The patient underwent incision biopsy and received systemic chemotheraphy and focal-field radiotheraphy. Cağavi et al. reported primary spinal extranodal Hodgkin's disease. Radiotheraphy was applied after surgery [3]. Citow et al. [5] reported a case with primary extranodal Hodgkin's disease who underwent decompressive surgery accompanied with stabilization and radiotheraphy.
Reported cases with primary spinal epidural Hodgkin's lymphoma (S:surgery, RT:radiotheraphy, CT:chemotheraphy. E:epidural, V:vertebral, P:paraspinal)
| Reference . | Age(years)/Sex . | Location . | MRI findings . | Treatment . | Survival (months) . |
|---|---|---|---|---|---|
| Rao et al. 1982 (6) | ?/? | ? | ? | S, RT | ? |
| Moridaira et al. 1994 (4) | 56/male | T8-10 | E, V | S, CT | ? |
| Citow et al. 2001 (5) | 54/female | T4-5 | E, V, P | S, RT | 24 |
| Cağavi et al. 2006 (3) | 39/male | L3, C6 | E, V, P | S, RT | 13 |
| Al-Khayat et al. 2007 (1) | 42/female | C7-T1 | E, P | S, RT, CT | 12 |
| Samadian et al. 2009 (2) | 12/male | L1-3 | E | S, RT, CT | 84 |
| Yaman et al., present case | 30/male | T9-11 | E, V, P | S, CT | 24 |
| Reference . | Age(years)/Sex . | Location . | MRI findings . | Treatment . | Survival (months) . |
|---|---|---|---|---|---|
| Rao et al. 1982 (6) | ?/? | ? | ? | S, RT | ? |
| Moridaira et al. 1994 (4) | 56/male | T8-10 | E, V | S, CT | ? |
| Citow et al. 2001 (5) | 54/female | T4-5 | E, V, P | S, RT | 24 |
| Cağavi et al. 2006 (3) | 39/male | L3, C6 | E, V, P | S, RT | 13 |
| Al-Khayat et al. 2007 (1) | 42/female | C7-T1 | E, P | S, RT, CT | 12 |
| Samadian et al. 2009 (2) | 12/male | L1-3 | E | S, RT, CT | 84 |
| Yaman et al., present case | 30/male | T9-11 | E, V, P | S, CT | 24 |
Reported cases with primary spinal epidural Hodgkin's lymphoma (S:surgery, RT:radiotheraphy, CT:chemotheraphy. E:epidural, V:vertebral, P:paraspinal)
| Reference . | Age(years)/Sex . | Location . | MRI findings . | Treatment . | Survival (months) . |
|---|---|---|---|---|---|
| Rao et al. 1982 (6) | ?/? | ? | ? | S, RT | ? |
| Moridaira et al. 1994 (4) | 56/male | T8-10 | E, V | S, CT | ? |
| Citow et al. 2001 (5) | 54/female | T4-5 | E, V, P | S, RT | 24 |
| Cağavi et al. 2006 (3) | 39/male | L3, C6 | E, V, P | S, RT | 13 |
| Al-Khayat et al. 2007 (1) | 42/female | C7-T1 | E, P | S, RT, CT | 12 |
| Samadian et al. 2009 (2) | 12/male | L1-3 | E | S, RT, CT | 84 |
| Yaman et al., present case | 30/male | T9-11 | E, V, P | S, CT | 24 |
| Reference . | Age(years)/Sex . | Location . | MRI findings . | Treatment . | Survival (months) . |
|---|---|---|---|---|---|
| Rao et al. 1982 (6) | ?/? | ? | ? | S, RT | ? |
| Moridaira et al. 1994 (4) | 56/male | T8-10 | E, V | S, CT | ? |
| Citow et al. 2001 (5) | 54/female | T4-5 | E, V, P | S, RT | 24 |
| Cağavi et al. 2006 (3) | 39/male | L3, C6 | E, V, P | S, RT | 13 |
| Al-Khayat et al. 2007 (1) | 42/female | C7-T1 | E, P | S, RT, CT | 12 |
| Samadian et al. 2009 (2) | 12/male | L1-3 | E | S, RT, CT | 84 |
| Yaman et al., present case | 30/male | T9-11 | E, V, P | S, CT | 24 |
Moridaira et al. [4] reported a case of Hodgkin's disease at T8–10 epidural space. Rao et al. [6] published a case with primary spinal epidural Hodgkin's lymphoma. Our case is apparently the seventh case to be diagnosed with Hodgkin's disease who presented with spinal cord compression due to epidural space without lymphoma elsewhere. The abnormal MRI marrow signal of the T9 and T10 vertebral bodies can be seen in Fig. 5. Maybe the tumor in fact originated within the abnormal T9 or T10 bone marrow and spread to the epidural space via the epidural venous plexus. But histological examination of the vertebral body revealed no abnormality.
Surgery is the first therapeutic approach in malignancies compressing the spinal cord. Because Hodgkin's lymphoma is a very chemosensitive and radiosensitive tumor, the indications for surgery were reduced and limited to laminectomy or even biopsy only, leaving the major role to chemotheraphy and radiotheraphy. The combination of chemotheraphy and involved-field radiotheraphy is the most common treatment strategy; two to four cycles of ABVD are considered as the international gold standard for early-stage Hodgkin's lymphoma in combination with 20–30 Gy of involved-field radiotheraphy [7, 8]. We chose the first therapeutic approach for this patient who underwent gross total resection of the tumor, because the tumor type was unknown at the time of initial presentation. Also, there was severe thoracal spinal cord compression on MRI of our case. Then, the patient was given six courses of chemotheraphy through ABVD regimen.
CONCLUSION
The present case demonstrated that physicians should include primary spinal epidural Hodgkin's lymphoma in the differential diagnosis of spinal tumors. Treatment of Hodgkin's lymphoma will almost always include in the acute phase a form of emergency decompressive surgery, with or without resection, followed by chemotheraphy and/or radiotheraphy.